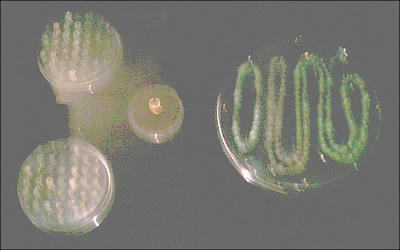

Music : Beatles "Mr.lonely"
Music : Beatles "Mr.lonely"



上右は、三重県の宝塚古墳から出土した「古墳時代の船」のレプリカ。<遺跡巡りの「宝塚古墳」を参照されたし。>
下は我が故郷福岡県の竹原古墳と、朝倉の「珍敷塚(めずらしづか)古墳」の装飾壁画「あの世への船」のレプリカ。

























 邪馬台国大研究・ホームページ / 博物館・資料館めぐり / 九州国立博物館
邪馬台国大研究・ホームページ / 博物館・資料館めぐり / 九州国立博物館 
 Music : Beatles "Mr.lonely"
Music : Beatles "Mr.lonely"

邪馬台国大研究・ホームページ / 博物館・資料館めぐり / 九州国立博物館
邪馬台国大研究・ホームページ / 博物館・資料館めぐり / 九州国立博物館 